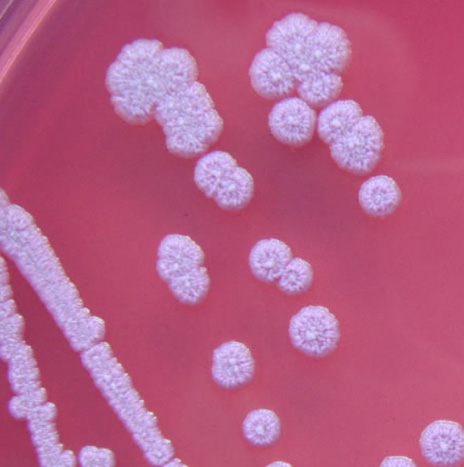
Vaccine Target Validation

Bacterial Vaccines Solution
Creative Biolabs is a leading professional developer and preclinical service provider of bacterial vaccines. It offers one-stop services from bacterial vaccine antigen screening to preclinical evaluation. Services include vaccine design, screening, optimization, and comprehensive preclinical assessments like in vitro/in vivo testing, safety and immunogenicity analyses. With advanced technical platforms and expert teams, it delivers efficient, reliable customized solutions to accelerate clients' bacterial vaccine R&D processes.
Talk To Our Bacterial Vaccine Experts View Services Available products
What is bacterial vaccine?
Bacterial vaccines are biological preparations designed to induce active immunity against pathogenic bacteria by exposing the immune system to bacterial components or attenuated/inactivated whole cells. These vaccines typically contain antigens such as capsular polysaccharides, toxoids (inactivated toxins), purified proteins, or whole bacteria (either live-attenuated or killed). Upon administration, they stimulate the production of memory T cells and antibodies, enabling the host to mount a rapid and specific immune response upon future exposure to the target pathogen.
Comprehensive Bacterial Vaccines Preclinical Solutions
Creative Biolabs offers cutting-edge preclinical solutions for bacterial vaccine development, specializing in innovative vaccine design and robust validation. Our services empower researchers to tackle infectious diseases by delivering tailored, high-quality vaccine candidates through advanced technologies and multidisciplinary expertise. Whether targeting emerging pathogens or challenging bacterial strains, we provide end-to-end support from antigen discovery to preclinical evaluation, with a strong emphasis on vaccine design innovation.
Comprehensive Service Portfolio
Vaccine Design Adjuvant selection Analysis & ValidationFormulation Development Preclinical Testing
Customized Bacterial Vaccine Design
-
Targeted Solutions: Tailored vaccine design for bacterial pathogens (e.g., Streptococcus, Salmonella, Mycobacterium) and their virulence factors (e.g., toxins, surface antigens).
-
Multi-Target Strategies: Development of multivalent or multi-epitope vaccines to combat antigenic variation and enhance broad-spectrum protection.
-
Technology Integration: Utilize recombinant protein expression, DNA vaccine technologies, and bacterial vector systems (e.g., attenuated Listeria, Shigella) for efficient antigen delivery.
Adjuvant Development & Optimization
-
Enhanced Immune Response: Selection and optimization of adjuvants (e.g., aluminum salts, TLR agonists) to boost humoral and cellular immunity against bacterial antigens.
-
Mechanistic Validation: In vitro and in vivo screening to assess adjuvant efficacy in antigen presentation and immune memory formation.
Analytical Development & Preclinical Validation
-
Quality Control Assays: Development of antigen quantification, purity analysis (e.g., HPLC, ELISA), and contaminant detection.
-
Immunogenicity Assessment: In vitro cytokine profiling, antibody titration, and functional assays (e.g., serum bactericidal activity) to validate vaccine performance.
-
Safety Testing: Preclinical toxicity evaluations and microbiological purity testing.
Formulation & Process Development
-
Stability Optimization: Customized formulation design for bacterial vaccines, including lyophilization and emulsion techniques to maintain antigen integrity.
-
Scalable Manufacturing: Development for recombinant protein production, bacterial vector engineering, and purification, supported by state-of-the-art fermentation systems.
Preclinical Testing
-
In Vivo Efficacy Studies: Animal model validation (rodents, non-human primates) for vaccine protective efficacy, including challenge studies and immune correlate analysis.
Getting Started with Your Bacterial Vaccine Project
Contact us via form submission or email us to discuss your project–we will promptly follow up with you.
Professional Vaccine Solution platform
Why Choose our Bacterial Vaccines Services?
Comprehensive Bacterial Vaccine Solutions
Creative Biolabs offers a full spectrum of bacterial vaccine products, utilizing diverse technical approaches. These include whole-cell vaccines, capsular polysaccharide and conjugate vaccines, toxoid vaccines, and purified protein vaccines.
Extensive coverage of bacterial disease prevention scenarios
Services offer vaccines for common (diphtheria, tetanus) and special-scenario (typhoid, cholera) bacterial diseases, covering diverse pathogens for research needs.
High-quality preparation processes and immunogenicity assurance
Services use precise pathogen culture/inactivation for inactivated vaccines, attenuation for live ones, and purification/conjugation for polysaccharide/toxoid vaccines.
Leading scientific research service capabilities in the industry
Full-process solutions from vaccine design/preparation to QC support research needs; customized vaccines meet basic/preclinical research requirements.
Available Products
Bacterial Antigen Products
Creative Biolabs offers ready-to-use bacterial antigens to accelerate research timelines, while also providing customized antigen solutions tailored to specific experimental needs upon request
Bacterial Antibody Products
Creative Biolabs delivers off-the-shelf bacterial antibodies to streamline research workflows, with custom antibody design services available for specialized applications.
FAQs
-
What are the key challenges in bacterial vaccine development?
Bacterial vaccine development faces challenges like antigenic variability, strain diversity, and the ability of bacteria to evade the immune system. Researchers must carefully select antigens that elicit a protective immune response while overcoming these obstacles, ensuring the vaccine remains effective across different strains of the pathogen.
-
How are bacterial antigens selected for vaccine design?
Antigen selection for bacterial vaccines focuses on identifying proteins or polysaccharides essential for bacterial survival or pathogenicity. These antigens must induce a robust immune response. Advances in genomics and proteomics aid in selecting conserved antigens across multiple strains, optimizing vaccine efficacy.
-
What role do adjuvants play in bacterial vaccines?
Adjuvants are critical in bacterial vaccines, particularly for those using inactivated or subunit antigens. They enhance the immune response, boosting antigen presentation and activation of immune cells. Without adjuvants, some bacterial vaccines may not elicit sufficient immunity, particularly in cases where the antigen alone is weakly immunogenic.
-
How does bacterial strain diversity affect vaccine efficacy?
Bacterial strain diversity complicates vaccine design as a single strain may not represent the entire pathogen population. Vaccines targeting conserved antigens across strains are preferred to maximize cross-protection, but high variability often necessitates multi-valent vaccines that include antigens from multiple strains for broader efficacy.
-
Why are some bacterial vaccines live-attenuated while others are inactivated?
Live-attenuated bacterial vaccines are used when strong, long-lasting immunity is needed, and the bacteria can be safely weakened. Inactivated vaccines are used when live bacteria may pose a risk, especially for immunocompromised individuals, focusing on safety while still stimulating a protective immune response.
-
What role does genetic engineering play in bacterial vaccine development?
Genetic engineering is vital in bacterial vaccine design, enabling the modification of bacterial antigens or the creation of recombinant proteins that enhance immune recognition. It allows for more precise control over the vaccine's components and can help develop vaccines for bacteria that are difficult to culture or attenuate.
Related Resources